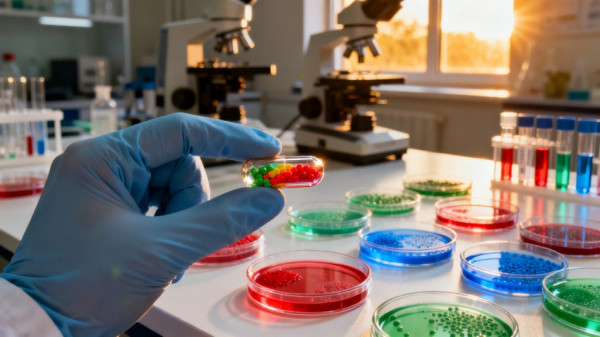

Восемь новых съедобных вакцин разрабатывают российские ученые
В Институте экспериментальной медицины ведется работа над инновационными вакцинами. Ученые используют пробиотики для защиты от вирусов и грибков. Проект стартовал во время пандемии. Ожидаются новые подходы к профилактике заболеваний.
В Институте экспериментальной медицины в России идет активная работа по созданию сразу восьми съедобных вакцин, которые предназначены для борьбы с различными вирусными и грибковыми инфекциями. Как сообщает 78.ru, специалисты института сосредоточились на разработке препаратов, способных защитить организм от гриппа, пневмококка и стрептококка группы В, который особенно опасен для новорожденных.
По словам заведующего отделом молекулярной микробиологии им. акад. РАН А.А. Тотоляна Александра Суворова, идея создания съедобных вакцин возникла в разгар пандемии коронавируса. Тогда ученые начали экспериментировать с мукозальными вакцинами на основе пробиотиков. Суть метода заключается в том, чтобы внедрить в генетическую структуру бактерии фрагмент вируса, после чего бактерия становится носителем антигена и способна вызывать иммунный ответ у человека.
На сегодняшний день в институте уже разработаны два варианта вакцины против гриппа, а также препарат для профилактики пневмококковой инфекции. Кроме того, ученые представили три новых варианта вакцины против стрептококка группы В. Этот патоген считается одной из главных причин смертности среди новорожденных, поэтому создание эффективной защиты от него имеет особое значение для медицины.
Интересно, что метод с использованием пробиотиков оказался весьма перспективным. По информации 78.ru, внедрение антигенов в структуру бактерий позволяет формировать устойчивую иммунную защиту, не прибегая к традиционным инъекциям. Такой способ может значительно упростить вакцинацию, сделать ее более доступной и безболезненной, особенно для детей и людей с хроническими заболеваниями.
В последние годы российские ученые все чаще обращаются к инновационным методам профилактики инфекций. скажем, недавно в стране стартовали клинические испытания первой вакцины от аллергии на пыльцу березы. Это подтверждает тенденцию к поиску новых решений в области иммунопрофилактики.
Стоит отметить, что ситуация с вирусными заболеваниями в России остается напряженной. В частности, в Санкт-Петербурге зафиксирован рост заболеваемости ОРВИ, о чем подробно говорится в материале Peterburg2.ru о динамике вирусных инфекций. Это подчеркивает актуальность разработки новых вакцин и поиска эффективных способов защиты населения.
Как отмечают эксперты, съедобные вакцины могут стать настоящим прорывом в профилактике инфекций. Их внедрение позволит не только повысить уровень коллективного иммунитета, но и снизить нагрузку на систему здравоохранения. В ближайшие годы ожидается появление новых препаратов, которые изменят метод к вакцинации в России.